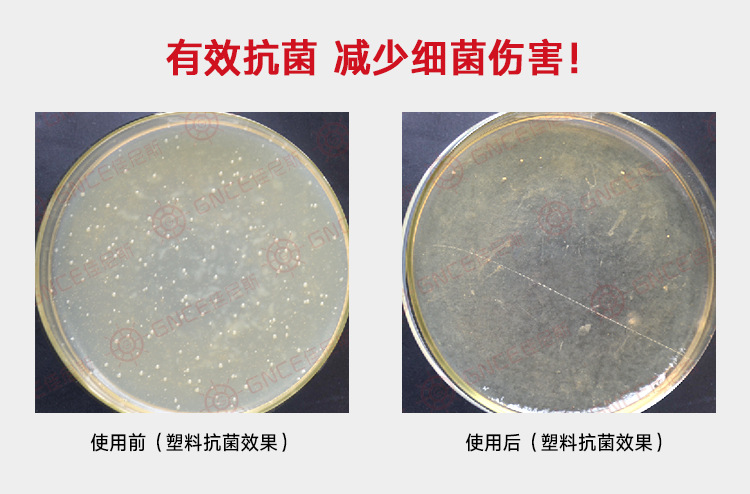

电话:
电话:
020-86532540
 手机:
手机:
18102206864
 邮箱:
邮箱:
yangtao@gnce.cn
 地址:
地址:
广东省广州市花都区狮岭镇新花路21号福野工业园3栋3楼
 微信:
微信:
扫一扫添加技术工程师微信

产品介绍:
塑料抗菌剂AEM5700-MB可以添加到塑料中制成具有抗菌功能的塑料制品,防止微生物所引起的危害,使处理材具有抗菌功能。
1.广谱抗菌性:具有非常广泛的抗菌效果,对多种细菌都具明显抗菌效果。
2.抗菌效率高:对金黄色葡萄球菌、绿脓杆菌、大肠杆菌等多种微生物的抗菌率可达99%。
3.效果持久:抗菌成分的可长期缓慢释放达到有效杀菌浓度,从而达到持续具有抗菌效果。
4.热稳定性好,耐高温,分解温度大于300℃。
5.保存、运输和使用方便;
6.无毒性:对大鼠的急性经口LD50为4000mg/kg,急性经皮21天,处理量为250mg/kg时未发现有刺激现象,对眼睛有轻微刺激,对皮肤无刺激。其安全性得到美国FDA和EPA的认可,并进行了相关环保安全性检测。
表1 塑料抗菌剂AEM5700-MB杀菌作用
微生物 | 杀菌条件 | 微生物 | 杀菌条件 | ||
浓度/% | 时间/min | 浓度/% | 时间/min | ||
枯草芽孢杆菌芽孢 | 0.05 | >1 | 巨大芽孢杆菌 | 0.04 | >2.5 |
金黄色葡萄球菌 | 0.025 | >1 | 地衣芽孢杆菌芽孢 | 0.04 | >30 |
大肠杆菌 | 0.2 | >1 | 变形杆菌 | 0.02 | 20 |
酿酒酵母 | 1.0 | >3 | 白色念球菌 | 0.08 | 15 |
黑曲霉 | 2.0 | >60 | 肺炎克雷百氏菌 | 0.04 | 20 |
蜡状芽孢杆菌芽孢 | 0.08 | >30 | 铜绿假单胞杆菌 | 0.2 | >3 |
产品属性:
外观:白色颗粒状
气味:无气味
表观密度:0.67g/mL
粒径:1-2mm
保质期:36 个月
包装及运输:
包装:5Kg、25kg 桶包装。
运输和储存:遵守化学品贮运的一般卫生安全规定,不可吞服。应避免阳光直晒,未开封之原装容器内,在干燥、
阴凉条件下。
应用范围:
◎塑料如 PE、PP、TPU、TPR 等
使用方法:
直接添加,使用比例为 0.3%~0.5%,可在小于 300℃的温度条件下使用。以下为一种注塑的工业流程图:

温馨提示:
1.使用时勿接触到眼睛或鼻子,以免造成皮肤接触过敏,操作过程中请佩戴口罩和橡胶手套;
2.若抗菌剂不慎接触皮肤,请及时用肥皂水彻底清洗;
3.初次使用请根据产品的颜色、透明度、相容性等是否符合要求进行加工工艺测试。
效果展示:
